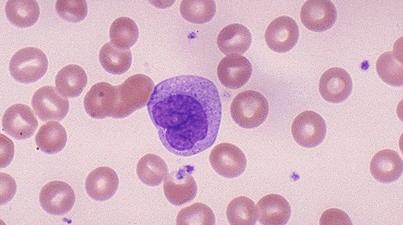

Моноциты — это вид белых кровяных клеток, важный для иммунной системы. Уровень моноцитов в крови может изменяться под воздействием различных факторов. Понижение их количества у женщин может свидетельствовать о заболеваниях или нарушениях. В статье рассмотрим причины снижения моноцитов, их влияние на здоровье и важность диагностики. Понимание этих аспектов поможет женщинам лучше следить за своим здоровьем и своевременно реагировать на проблемы.
Влияние на организм
Моноциты представляют собой крупные клетки, относящиеся к группе лейкоцитов, и играют ключевую роль в функционировании иммунной системы. Эти клетки активно циркулируют в крови, а также находятся в лимфатических узлах, селезенке и печени. Формирование моноцитов происходит в костном мозге, откуда они затем попадают в кровоток.
К основным функциям моноцитов можно отнести:
- уничтожение патогенных микроорганизмов;
- удаление из тканей вредных бактерий и разрушенных клеток;
- защита организма от образования опухолей;
- участие в регенерации тканей и процессах кроветворения.
Моноциты оказывают токсическое воздействие на паразитов, которые проникают в человеческий организм. Если уровень моноцитов отклоняется от нормы, это может привести к снижению защитных функций лейкоцитов, что, в свою очередь, создает благоприятные условия для размножения вредоносных бактерий и микроорганизмов в органах и тканях.
Медицинские специалисты отмечают, что пониженный уровень моноцитов у женщин может быть вызван различными факторами. Одной из основных причин является снижение иммунной функции, что может происходить при хронических инфекциях или аутоиммунных заболеваниях. Врачи также указывают на возможность влияния стресса и недостатка сна, которые негативно сказываются на общем состоянии организма. Кроме того, недостаток витаминов и минералов, таких как витамин B12 и фолиевая кислота, может привести к снижению уровня моноцитов. Важно отметить, что такие изменения могут быть временными и не всегда требуют серьезного вмешательства. Однако, если пониженные моноциты сопровождаются другими симптомами, рекомендуется обратиться к врачу для дальнейшего обследования и выявления причин.
https://youtube.com/watch?v=GPHJ8zx4x08
Показатель нормы
Анализ крови позволяет определить уровень моноцитов, который выражается в процентах и отражает их долю среди всех белых кровяных клеток.
Уровень этих клеток остается практически неизменным на протяжении всей жизни человека и имеет схожие показатели как у взрослых, так и у детей старше 13 лет.
| Причина | Описание | Дополнительные факторы |
|---|---|---|
| Апластическая анемия | Редкое заболевание, при котором костный мозг не производит достаточное количество всех типов клеток крови, включая моноциты. | Воздействие токсинов, радиации, некоторые лекарства, вирусные инфекции. |
| Химиотерапия и лучевая терапия | Лечение рака, которое подавляет активность костного мозга, снижая выработку клеток крови. | Доза и продолжительность лечения, тип используемых препаратов. |
| Инфекции (острые и хронические) | Некоторые тяжелые инфекции, особенно вирусные (например, ВИЧ, грипп), могут временно подавлять выработку моноцитов. | Тяжесть инфекции, состояние иммунной системы. |
| Аутоиммунные заболевания | Состояния, при которых иммунная система атакует собственные здоровые клетки, включая клетки костного мозга. | Системная красная волчанка, ревматоидный артрит. |
| Прием некоторых лекарств | Некоторые препараты, такие как кортикостероиды, иммунодепрессанты, могут снижать количество моноцитов. | Дозировка и длительность приема препарата. |
| Стресс и истощение | Длительный или сильный стресс может влиять на работу иммунной системы и кроветворение. | Хронический стресс, недосыпание, переутомление. |
| Дефицит питательных веществ | Недостаток некоторых витаминов и минералов, необходимых для нормального кроветворения. | Дефицит витамина B12, фолиевой кислоты, железа. |
| Наследственные заболевания | Редкие генетические нарушения, влияющие на производство клеток крови. | Синдром Костманна, врожденная нейтропения. |
| Заболевания костного мозга | Некоторые заболевания, поражающие костный мозг, могут нарушать производство моноцитов. | Миелодиспластический синдром, лейкемия (на определенных стадиях). |
| Послеоперационный период | Временное снижение моноцитов может наблюдаться после обширных хирургических вмешательств. | Объем операции, наличие осложнений. |
Для детей
У здоровых детей общий анализ крови демонстрирует содержание моноцитов в пределах 2-12% от общего числа лейкоцитов.
У новорожденных и детей до одного года этот показатель значительно выше, чем у взрослых. Это связано с тем, что в первые месяцы жизни малыш только начинает приспосабливаться к окружающей среде и особенно нуждается в защите от различных негативных факторов, поэтому наличие достаточного количества этих клеток крови является крайне важным.
https://youtube.com/watch?v=dGNq459J3hc
Для взрослых
У людей старше 13 лет нормальный уровень моноцитов варьируется от 3 до 11% от общего количества лейкоцитов.
Эти оптимальные показатели свидетельствуют о том, что в организме отсутствуют вредные бактерии и паразиты, а также о том, что отмершие клетки эффективно удаляются и усваиваются.
Как определить низкий уровень моноцитов: диагностика и симптомы
При снижении уровня моноцитов на 1-3% может развиться моноцитопения, что приводит к значительному ослаблению иммунной системы и снижению количества лейкоцитов, хотя такие случаи встречаются не так часто.
Для определения уровня моноцитов необходимо провести анализ крови, взяв образец из пальца. Чтобы избежать возможных ошибок в результатах, следует заранее подготовиться к этой процедуре:
- за 3-4 дня до анализа постарайтесь не принимать медикаменты;
- за сутки до процедуры избегайте физических нагрузок и стрессовых ситуаций;
- за 2-3 дня до анализа исключите алкоголь, жирную и острую пищу, а также воздержитесь от курения.
Анализ крови рекомендуется сдавать утром натощак, поэтому последний прием пищи должен быть не менее чем за 8 часов до процедуры. Если результаты покажут отклонения от нормы, может потребоваться повторный анализ.
При снижении уровня моноцитов могут наблюдаться следующие симптомы:
- головные боли;
- воспаление десен и слизистой рта;
- небольшое, но продолжительное повышение температуры.
Сниженные моноциты часто приводят к повышенной утомляемости и могут способствовать развитию грибковых инфекций.
Причины пониженного уровня
Факторы, влияющие на уровень клеток, можно разделить на физиологические и патологические. К физиологическим причинам относятся:
- длительное голодание (например, строгие и несбалансированные диеты);
- высокая физическая активность (тяжелая работа, чрезмерные тренировки);
- постоянные стрессовые ситуации.
Снижение уровня моноцитов в крови может наблюдаться в послеоперационный период или при использовании некоторых медикаментов.
На состояние здоровья и результаты анализов негативно влияют:
- онкологические заболевания;
- заболевания печени (гепатит);
- инфекционные болезни (например, брюшной тиф), которые могут вызывать «перерасход» клеток;
- тяжелые формы первичного туберкулеза;
- анемия, особенно если она связана с нарушениями в костном мозге.
Отрицательное воздействие также оказывают отравления химическими веществами, развитие гнойных процессов (гангрена), а также длительный прием некоторых гормональных препаратов, например, при лечении ревматоидного артрита или бронхиальной астмы. В редких случаях при проведении анализа может быть обнаружено отсутствие моноцитов, что может указывать на серьезные заболевания, такие как лейкоз или сепсис.
Снижение у взрослых
Сниженное количество моноцитов в крови у взрослого человека может быть вызвано перечисленными ранее факторами. Однако у женщин такой дефицит клеток может возникнуть во время беременности или в процессе родов.
Если во время беременности наблюдается длительное снижение уровня моноцитов, это может негативно сказаться на развитии плода. В некоторых случаях врач может рекомендовать применение глюкокортикостероидных препаратов. Обычно через несколько недель после родов показатели анализов возвращаются к норме.
Снижение у детей
Ключевые причины, приводящие к снижению уровня моноцитов у детей, аналогичны тем, что наблюдаются у взрослых. Однако показатели могут варьироваться из-за интенсивного физиологического развития в период роста, что зачастую считается нормальным явлением. Снижение количества этих клеток у детей также может происходить на фоне глистной инвазии. В таких ситуациях обычно назначается курс антибиотиков для лечения.
Часто ухудшение показателей крови у мужчин, женщин и детей связано с неправильной подготовкой к анализу.
В чем опасность и последствия моноцитопении
Узнав о низком уровне моноцитов, не каждый осознает, что это означает. В таких ситуациях происходит ослабление иммунной системы, что приводит к снижению ее защитных функций. В результате возрастает риск развития различных заболеваний, среди которых наиболее опасным является заражение крови.
При ослабленном иммунитете даже небольшое воспаление может перерасти в абсцесс, а клетки теряют способность распознавать патогенные микроорганизмы, что приводит к тому, что организм не пытается избавиться от них.
Часто длительное воспаление может стать причиной перитонита, для лечения которого требуется хирургическое вмешательство.
Поэтому крайне важно регулярно проходить обследования и сдавать анализы, чтобы вовремя выявить отклонения от нормы и назначить адекватное лечение.
Методы лечения и профилактики моноцитопении
Лечение моноцитопении сосредоточено на выявлении причин, которые привели к этому состоянию, поскольку нет специфической терапии для увеличения количества клеток. Здесь важен индивидуальный подход к каждому пациенту.
В некоторых случаях достаточно устранить физиологические факторы: изменить рацион питания и снизить чрезмерные физические нагрузки. В других ситуациях может потребоваться применение медикаментов для лечения основного заболевания, вызвавшего снижение уровня клеток.
Чтобы повысить количество моноцитов или предотвратить их снижение, рекомендуется следовать нескольким простым правилам:
- ежедневно гулять на свежем воздухе;
- включить в рацион печень, гречку, шпинат и чеснок;
- разнообразить меню орехами, абрикосами (курагой) и ягодами;
- готовить отвар из шиповника, а также заваривать кофе или чай из цикория.
В домашних условиях, при отсутствии противопоказаний, полезно употреблять свекольный сок и овсяный отвар.
Важно помнить, что такие методы эффективны только при непатологических формах моноцитопении. Они помогают стимулировать иммунную систему и укрепляют защитные силы организма.
Не следует самостоятельно, без назначения врача, принимать иммуностимулирующие препараты, так как их использование должно быть строго контролируемым. Кроме того, любые лекарства имеют свои противопоказания.
Только квалифицированный специалист может учесть возможные последствия от приема препаратов, сопоставляя их с конкретными симптомами и тяжестью заболевания.
Снижение уровня моноцитов в организме может быть следствием серьезного заболевания как у взрослых, так и у детей. При обнаружении пониженного уровня этого показателя в крови необходимо срочно выяснить причину патологии — снижение моноцитов приводит к значительному ослаблению иммунной системы, и человек становится уязвимым для различных инфекций.
Происхождение моноцитов и их норма нахождения в крови
Моноциты представляют собой тип лейкоцитов, которые циркулируют в периферической крови и играют ключевую роль в поддержании иммунного баланса организма. Эти одноядерные клетки производятся в костном мозге.
Среди всех лейкоцитов моноциты выделяются своим крупным размером и высокой активностью. Их основная функция заключается в очищении организма от токсинов. Моноциты уничтожают и перерабатывают мертвые клетки, а также активно борются с патогенными микроорганизмами.
По своей роли в организме моноциты схожи с нейтрофилами, однако, в отличие от последних, они способны функционировать в кислых средах, не теряя своей эффективности. Жизненный цикл моноцита составляет до 40 часов, после чего они покидают плазму и проникают в ткани, где превращаются в макрофаги.
Важно отметить, что функции моноцитов не ограничиваются только очищением. Они также участвуют в процессе кроветворения, способствуют восстановлению поврежденных тканей после травм и вырабатывают токсины, которые помогают бороться с микроорганизмами.
С возрастом количество моноцитов в организме увеличивается. Нормальные показатели для мужчин и женщин варьируются от 3 до 11%, что соответствует абсолютному количеству 0,09-0,6х10^9/л клеток. У детей эти значения несколько ниже и составляют от 2 до 12%, при этом с возрастом ребенка уровень моноцитов возрастает.
Если уровень моноцитов в крови снижен, это состояние называется моноцитопенией и может указывать на наличие болезненных процессов в организме пациента.
Причины моноцитопении
Когда уровень моноцитов в крови снижен, что это может означать? Уменьшение количества этих лейкоцитов в организме во время болезни, например, при серьезной инфекционной патологии, не всегда указывает на патологические изменения, связанные с нарушением иммунной системы. В условиях инфекции лейкоциты активно выполняют свои функции, направляясь в пораженные ткани, где участвуют в процессе восстановления. После завершения выздоровления уровень моноцитов обычно быстро восстанавливается до нормальных значений. Аналогичное снижение может наблюдаться у женщин во время беременности и сразу после родов.
Кроме указанных причин, снижение моноцитов может быть связано с рядом других заболеваний:
- облучение;
- опухолевые процессы в костном мозге;
- недавнее прохождение курса химиотерапии;
- отравления;
- превышение дозировки гормональных препаратов;
- образование антилейкоцитарных антител;
- подавление моноцитов токсическими веществами;
- стрессовые состояния;
- авитаминоз и общее ухудшение здоровья пациента.
Выявление моноцитопении и способы лечения
Внешние признаки моноцитопении могут отсутствовать, и анализ крови на уровень моноцитов может быть назначен в случаях, когда организм испытывает трудности с регенерацией тканей или часто страдает от заболеваний.
Для получения информации о количестве моноцитов в крови необходимо провести общий анализ, который выполняется на основе образца, взятого из пальца пациента. Рекомендуется сдавать анализ натощак, желательно утром, чтобы результаты были максимально точными.
Важно! Перед сдачей анализа на моноциты следует воздержаться от употребления алкоголя за 3-4 дня и не курить в день проведения теста.
Если уровень моноцитов снижен, врач может назначить дополнительные анализы для уточнения диагноза. Также будет проведен детальный опрос пациента, чтобы выяснить, какие симптомы могут указывать на наличие заболеваний.
Лечение моноцитопении медикаментозным путем невозможно без госпитализации, и в любом случае, терапия не назначается без ясного понимания причин снижения уровня моноцитов. Обычно восстановить нормальные показатели можно, придерживаясь сбалансированного питания, отказываясь от вредных привычек и ведя здоровый образ жизни. В случаях онкологических заболеваний или паразитарных инфекций может потребоваться применение медикаментов и комплексное лечение.
Попытки самостоятельно справиться с лейкопенией не приведут к желаемым результатам.
Только профессиональное медицинское вмешательство и лечение на основе точного диагноза способны помочь в борьбе с этой проблемой. Для профилактики моноцитопении рекомендуется ежегодно проходить медицинское обследование и сдавать анализ крови на общий анализ крови.
Моноциты представляют собой группу клеток, входящих в состав лейкоцитов. Они играют ключевую роль в иммунной системе человека, выполняя несколько важных функций: защищают от инфекций, борются с паразитами и опухолями, а также участвуют в процессе растворения тромбов.
Эти клетки оказывают значительное влияние на лимфоциты, что, в свою очередь, затрагивает всю систему кроветворения.
Обычно уровень моноцитов составляет 4-8%, и чаще всего наблюдается его повышение. Однако бывают случаи, когда количество этих клеток снижается, хотя низкий уровень моноцитов встречается реже, чем его увеличение.
Это не всегда указывает на наличие заболевания, но в большинстве случаев низкие показатели моноцитов, к сожалению, свидетельствуют о патологических процессах. Далее мы подробнее рассмотрим, что это может означать и какие факторы могут способствовать такому состоянию.
https://youtube.com/watch?v=r-x3JLQvwyg
Норма содержания моноцитов в крови
У здоровых взрослых и детей старше 13 лет нормальный уровень моноцитов в крови варьируется от 3 до 11% от общего числа лейкоцитов, что соответствует диапазону от 0,1 до 0,6 х 10^9/л.
У детей младше 13 лет содержание моноцитов в крови составляет от 2 до 12% от общего количества лейкоцитов.
Роль моноцитов в организме
Основная задача моноцитов заключается в поглощении мертвых тканей и активной борьбе с паразитами, микробами и опухолевыми образованиями. Эти клетки выполняют роль защитников чистоты крови и участвуют в её обновлении, поэтому их часто называют «дворниками организма».
Таким образом, моноциты играют ключевую роль в организме, в первую очередь обеспечивая:
- защиту от микробных инфекций;
- восстановление тканей;
- защиту от опухолей;
- фагоцитоз поврежденных и мертвых клеток;
- токсическое воздействие на паразитов, проникающих в организм человека.
Продолжительность жизни этих клеток крови составляет всего 3 дня, после чего они проникают в ткани и превращаются в тканевые макрофаги. Одной из главных функций этих клеток является их выраженная противоопухолевая активность. Кроме того, они также участвуют в выработке интерферона.
Причины пониженных моноцитов у взрослых
При снижении уровня моноцитов в крови у взрослого человека может возникнуть состояние, известное как моноцитопения. Это явление часто наблюдается у женщин в период беременности сразу после родов. Однако существуют и другие факторы, способные привести к уменьшению количества моноцитов как у взрослых, так и у детей. Важно отметить, что снижение уровня моноцитов в крови обычно сопровождается уменьшением и других видов лейкоцитов.
Давайте подробнее рассмотрим, что может означать пониженный уровень моноцитов у взрослого. Возможные причины включают:
- стрессовые ситуации и шок;
- операции и хирургические вмешательства;
- влияние ионизирующего излучения;
- химические отравления;
- апластическую анемию;
- общее истощение организма;
- тяжелые гнойные инфекции;
- длительный прием глюкокортикостероидов;
- серьезные инфекционные заболевания с понижением уровня нейтрофилов, такие как брюшной тиф;
- поражения костного мозга, так как именно в нем формируются моноциты перед попаданием в кровь.
Если результаты общего анализа крови показывают низкий уровень моноцитов, важно обратиться к врачу для предотвращения дальнейшего ухудшения состояния. Лечение моноцитопении заключается в устранении причин, вызвавших это состояние. В каждом конкретном случае подход к лечению может различаться. Иногда достаточно изменить рацион питания, чтобы увеличить количество клеток до нормального уровня. В других ситуациях может потребоваться применение специальных медикаментов или даже хирургическое вмешательство.
Пониженные моноциты у ребенка
Причины возникновения моноцитопении у детей аналогичны тем, что наблюдаются у взрослых. К числу таких причин относятся:
- острые инфекционные болезни;
- заболевания костного мозга;
- хирургические вмешательства;
- гнойные воспалительные процессы в организме;
- сепсис;
- истощение организма.
Снижение уровня моноцитов в крови у детей встречается значительно чаще, чем их повышение. Поскольку нормальные показатели моноцитов у ребенка зависят от его возраста, величина отклонения от нормы, при которой можно говорить о моноцитопении, также различается для разных возрастных категорий.
Что делать при низких моноцитах
Основное лечение при снижении уровня моноцитов сосредоточено на устранении причин, вызвавших это состояние. Каждый случай уникален, и врач может как назначить медикаменты, так и отменить уже применяемые препараты, которые могли способствовать снижению моноцитов в крови.
Обычно пациентам советуют придерживаться определённой диеты. В редких ситуациях, когда уровень моноцитов значительно понижен, может потребоваться вмешательство хирурга.
Влияние питания на уровень моноцитов
Питание играет ключевую роль в поддержании нормального уровня моноцитов в крови. Моноциты — это тип белых кровяных клеток, которые отвечают за иммунный ответ организма, и их уровень может значительно варьироваться в зависимости от рациона питания. Неправильное или несбалансированное питание может привести к снижению уровня моноцитов, что, в свою очередь, может ослабить иммунную систему и повысить риск инфекций.
Одним из основных факторов, влияющих на уровень моноцитов, является потребление достаточного количества витаминов и минералов. Например, недостаток витамина B12 и фолиевой кислоты может привести к анемии, что, в свою очередь, может снизить количество моноцитов. Эти витамины необходимы для нормального кроветворения и функционирования иммунной системы. Поэтому важно включать в рацион продукты, богатые этими витаминами, такие как мясо, рыба, яйца, молочные продукты, а также зеленые листовые овощи и бобовые.
Кроме того, недостаток железа также может негативно сказаться на уровне моноцитов. Железо необходимо для синтеза гемоглобина, который отвечает за транспортировку кислорода в организме. Низкий уровень железа может привести к снижению выработки клеток крови, включая моноциты. Продукты, богатые железом, такие как красное мясо, печень, бобовые, орехи и семена, должны быть включены в рацион, особенно для женщин, которые могут испытывать дефицит железа из-за менструаций.
Также стоит обратить внимание на потребление антиоксидантов, таких как витамины C и E, которые помогают защищать клетки от окислительного стресса и поддерживают иммунную систему. Фрукты и овощи, особенно ярких цветов, такие как цитрусовые, ягоды, шпинат и морковь, являются отличными источниками этих витаминов.
Не менее важным аспектом является баланс между углеводами, белками и жирами в рационе. Избыточное потребление простых углеводов и насыщенных жиров может привести к воспалительным процессам в организме, что может негативно сказаться на уровне моноцитов. Рекомендуется отдавать предпочтение сложным углеводам, таким как цельнозерновые продукты, а также полезным жирам, содержащимся в рыбе, авокадо и оливковом масле.
Наконец, важно учитывать, что режим питания также влияет на уровень моноцитов. Регулярные приемы пищи и сбалансированное питание способствуют поддержанию стабильного уровня сахара в крови и предотвращают резкие колебания, которые могут негативно сказаться на иммунной системе. Избегание пропусков в приеме пищи и чрезмерного потребления обработанных продуктов поможет поддерживать здоровье и нормальный уровень моноцитов.
Связь между стрессом и уровнем моноцитов
Стресс является одним из факторов, который может оказывать значительное влияние на уровень моноцитов в крови. Моноциты — это тип белых кровяных клеток, которые играют ключевую роль в иммунной системе, участвуя в защите организма от инфекций и воспалений. При хроническом стрессе происходит активация гипоталамо-гипофизарно-адреналовой системы, что приводит к повышению уровня кортизола — гормона стресса. Это, в свою очередь, может вызывать изменения в производстве и функции моноцитов.
Исследования показывают, что при длительном воздействии стресса уровень моноцитов может снижаться. Это связано с тем, что кортизол подавляет активность костного мозга, где происходит образование клеток крови, включая моноциты. Кроме того, стресс может приводить к изменению уровня других гормонов и цитокинов, что также может негативно сказываться на количестве моноцитов.
Важно отметить, что не только хронический, но и острый стресс может влиять на уровень моноцитов. В ответ на острые стрессовые ситуации, такие как травмы или хирургические вмешательства, организм может временно увеличивать уровень моноцитов, однако после разрешения стресса их количество может значительно снизиться.
Кроме того, стресс может способствовать развитию различных заболеваний, таких как депрессия или тревожные расстройства, которые также могут влиять на уровень моноцитов. Например, у женщин с депрессивными состояниями часто наблюдается снижение уровня моноцитов, что может быть связано с нарушением иммунной функции и увеличением воспалительных процессов в организме.
Таким образом, связь между стрессом и уровнем моноцитов является сложной и многогранной. Понимание этого взаимодействия может помочь в разработке стратегий по управлению стрессом и поддержанию нормального уровня моноцитов, что, в свою очередь, способствует улучшению общего состояния здоровья и укреплению иммунной системы.
Рекомендации по образу жизни для поддержания нормального уровня моноцитов
Поддержание нормального уровня моноцитов в крови является важным аспектом общего здоровья, особенно для женщин, которые могут сталкиваться с различными факторами, влияющими на уровень этих клеток. Моноциты играют ключевую роль в иммунной системе, и их пониженный уровень может указывать на наличие различных заболеваний или состояний. Чтобы поддерживать нормальный уровень моноцитов, важно обратить внимание на образ жизни и внести некоторые изменения в повседневные привычки.
1. Правильное питание: Рацион, богатый витаминами и минералами, способствует нормализации уровня моноцитов. Включение в меню продуктов, богатых витамином B12, фолиевой кислотой, железом и цинком, может помочь поддерживать здоровье крови. Рекомендуется употреблять больше свежих фруктов и овощей, цельнозерновых продуктов, нежирного мяса, рыбы и бобовых. Избегайте избыточного потребления сахара и обработанных продуктов, которые могут негативно сказаться на иммунной системе.
2. Регулярная физическая активность: Умеренные физические нагрузки, такие как прогулки, йога или плавание, способствуют улучшению кровообращения и укреплению иммунной системы. Физическая активность помогает организму лучше справляться со стрессом и поддерживать нормальный уровень клеток крови, включая моноциты. Рекомендуется заниматься спортом не менее 150 минут в неделю.
3. Управление стрессом: Хронический стресс может негативно влиять на уровень моноцитов и общее состояние здоровья. Практики релаксации, такие как медитация, глубокое дыхание и занятия хобби, могут помочь снизить уровень стресса. Важно находить время для отдыха и восстановления, чтобы поддерживать психоэмоциональное равновесие.
4. Достаточный сон: Качественный сон играет важную роль в поддержании иммунной системы. Недостаток сна может привести к снижению уровня моноцитов и ухудшению общего состояния здоровья. Рекомендуется спать не менее 7-8 часов в сутки и придерживаться режима сна, ложась и вставая в одно и то же время.
5. Регулярные медицинские обследования: Периодические визиты к врачу и сдача анализов помогут контролировать уровень моноцитов и выявлять возможные проблемы на ранних стадиях. Это особенно важно для женщин, которые могут быть подвержены различным заболеваниям, влияющим на уровень клеток крови.
Следуя этим рекомендациям, женщины могут поддерживать нормальный уровень моноцитов и, как следствие, укреплять свою иммунную систему и общее здоровье. Важно помнить, что любые изменения в образе жизни должны обсуждаться с врачом, особенно если имеются хронические заболевания или другие медицинские показания.